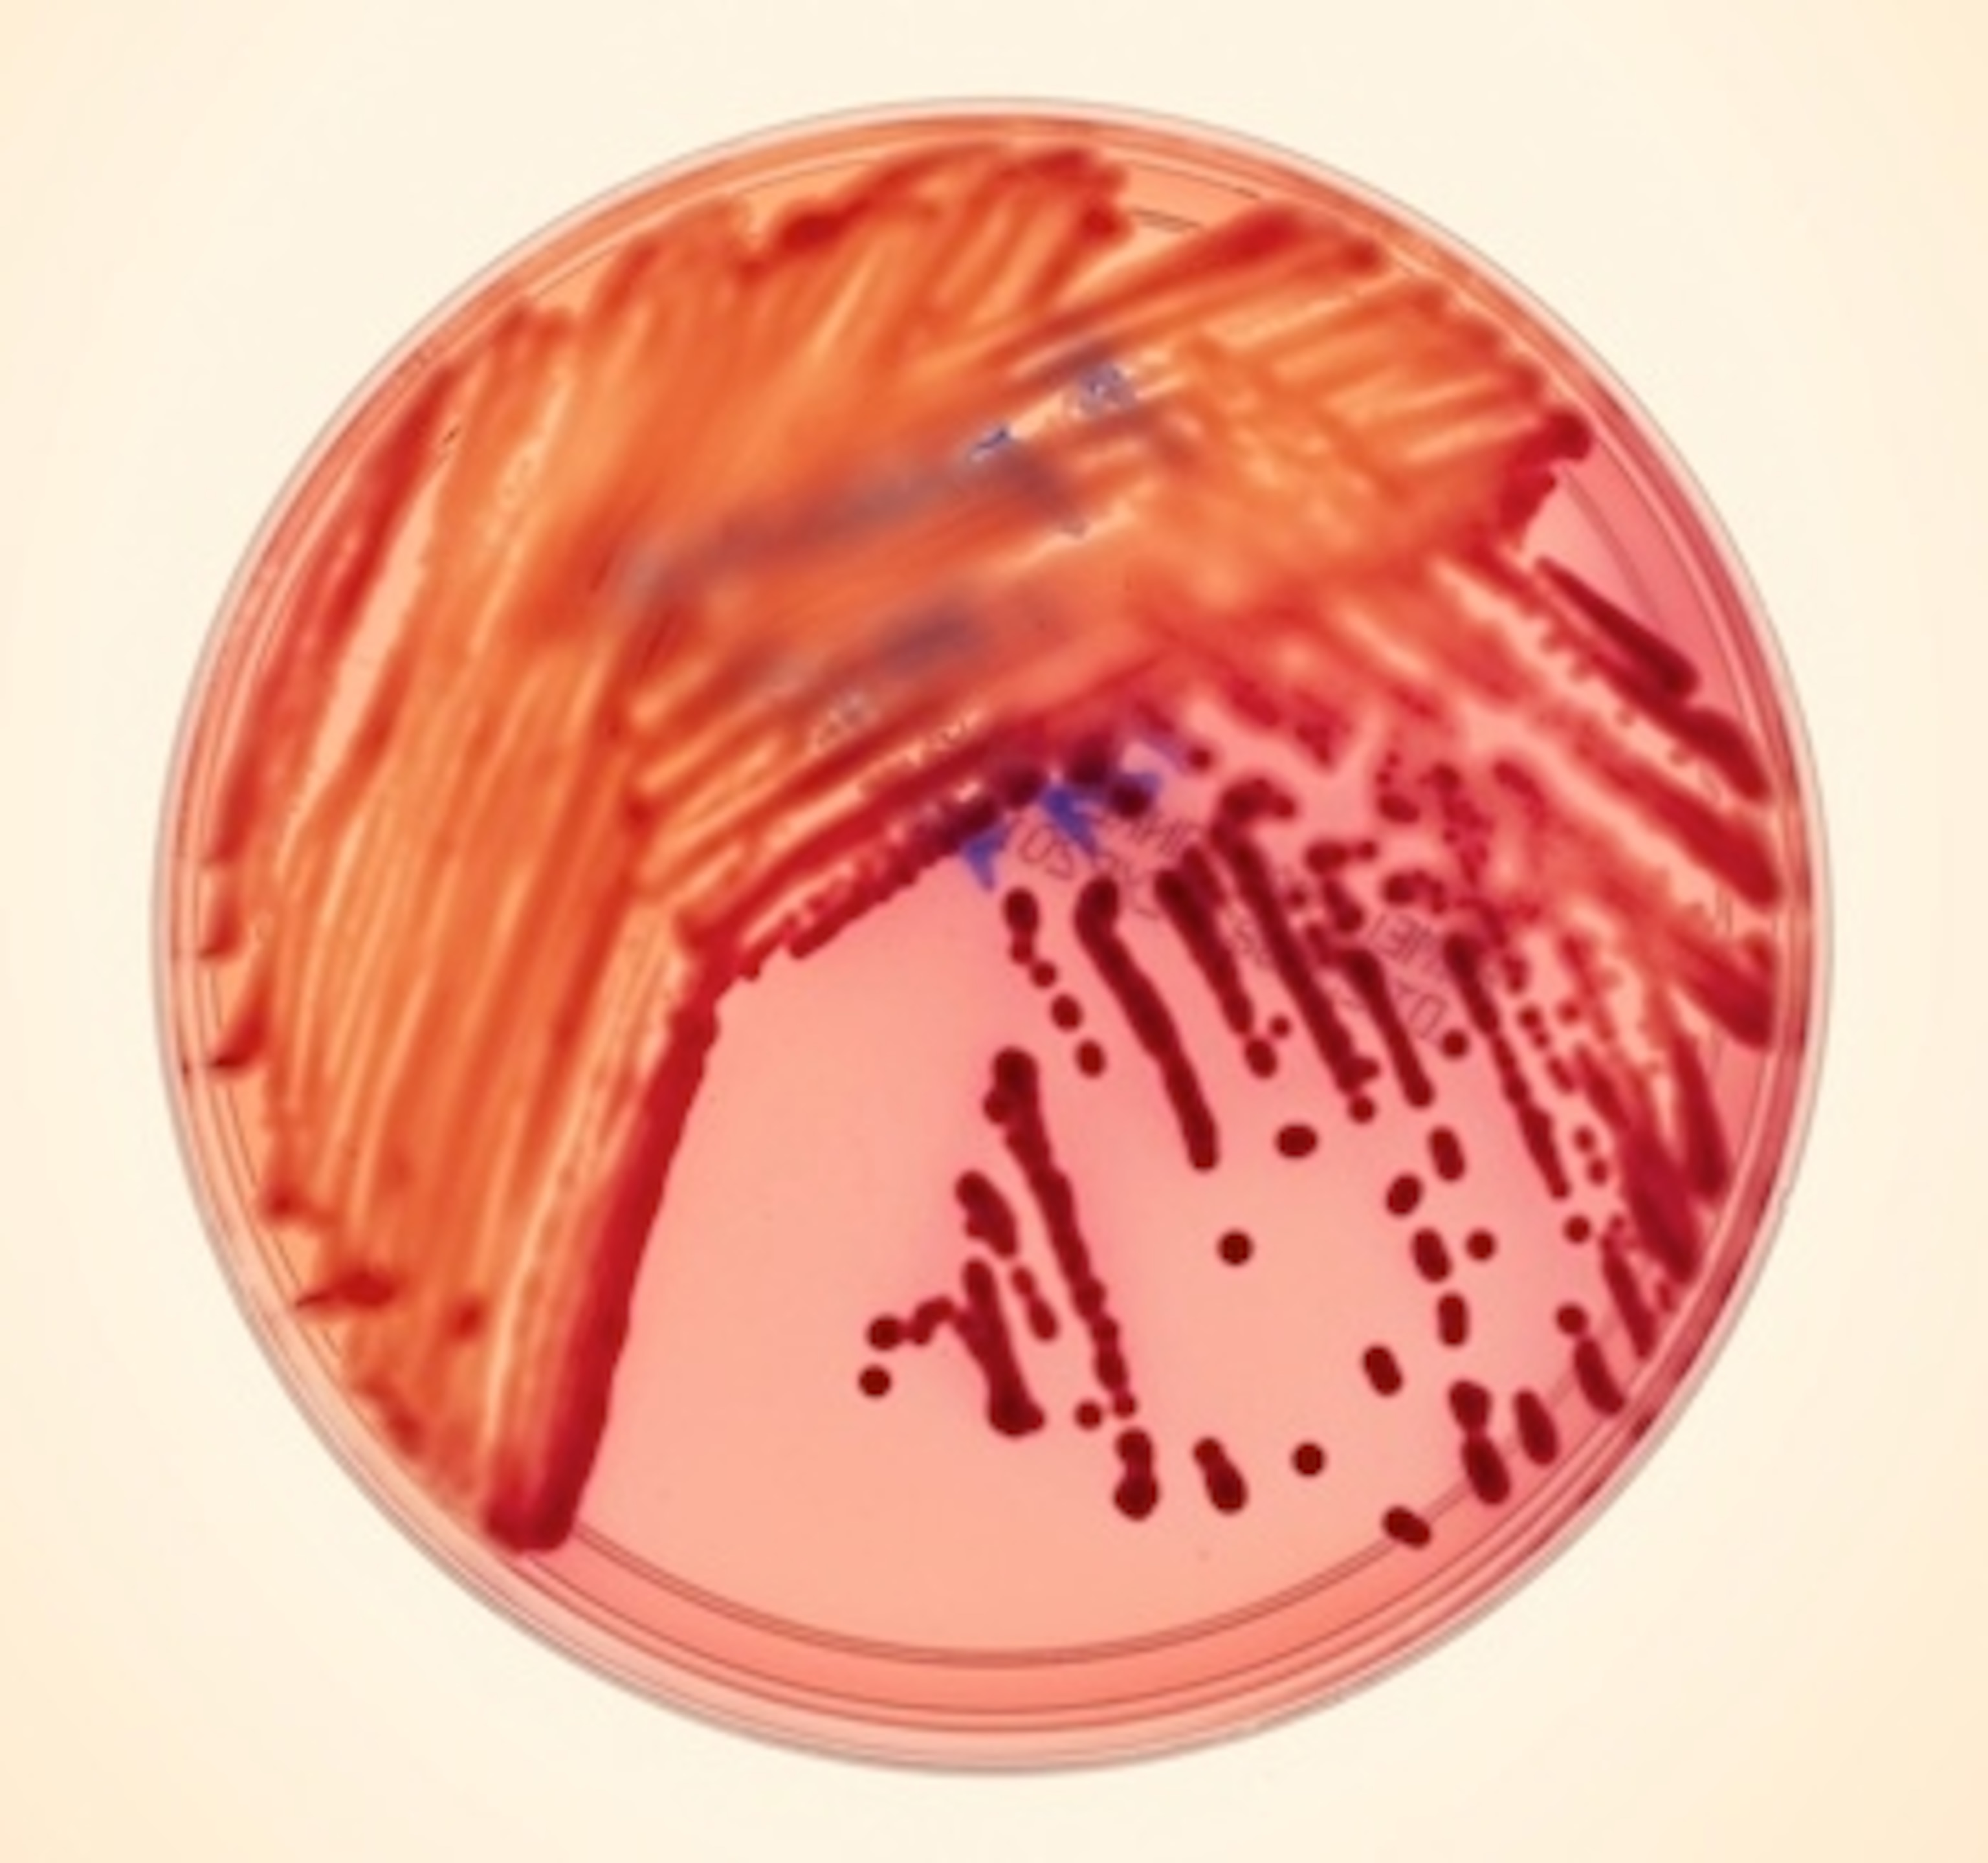

About 100,000 people die each year in the United States from infections they pick up in hospitals. Even the best hospitals in the country are not exempt from this disaster, and it’s getting worse: the bacteria that are attacking patients are becoming frighteningly resistant to antibiotics. Some are becoming resistant to everything doctors can throw at them.
I recently went to Bethesda, Maryland, to visit doctors who struggled with one of these outbreaks at the NIH Clinical Center, one of the country’s premiere research hospitals. Most hospitals stay pretty quiet about their outbreaks, but the Clinical Center staff was far more transparent. They were willing to take me around the hospital as they described their struggles to stop the bacteria, called KPC, as it crept mysteriously from patient to patient and from ward to ward.
The story of the outbreak is pretty grim. Months after it seemed over, another patient died from a KPC infection, meaning that the bacteria still lurk in the hospital. But there’s one ray of hope. The doctors at the hospital joined forces with genome-sequencing experts, who probed the DNA of the bacteria for clues to its spread. This was one of the first times that genome sequencing helped–in real time–in the fight against a hospital outbreak. In the next issue of Wired, I chronicle this extraordinary piece of detective work. You can read my feature online here.
As I write in the story, genome sequencing could potentially help a lot in the broader war against hospital-acquired infections. But it won’t make much difference unless hospitals are united in using the best tools possible. When the Clinical Center doctors headed out to other hospitals to offer the lessons they had learned, they were startled to find that KPC was a fixture in many of the other hospitals. The very fact that this information came as a surprise to them shows just how little communication there is between hospitals about their outbreaks.
Julie Segre, one of the genome experts who battled the KPC outbreak at the Clinical Center, is convinced that patients and their families can help push hospitals to start using genome sequencing and other new tools to battle outbreaks.
“When a patient thinks about where to go for a stem cell transplant or a chemotherapy treatment, they think about who has a better medical team,” she told me. “But if you’re really making that decision, one of the things you need to think about is, who has the best infection control? Who’s in the middle of an outbreak? That’s what I’d want to know.”
To see what twenty-first century infection control looks like, check out my story.